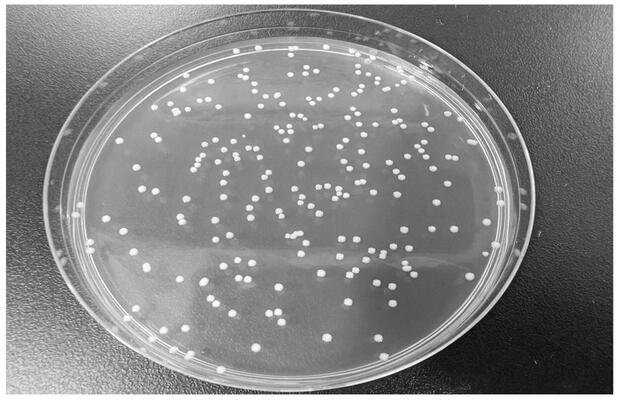
降脂降糖功能测试费用多少

办理一份降脂降糖功能测试报告的费用大概在 3000 至 10000 元左右。
一、检测费用明细
降脂降糖功能测试费用根据试验模型、指标数量与报告用途浮动,以下是常见方案预估价格:
| 检测项目 | 预估价格 |
| 细胞模型筛查(单项指标) | 3000-5000 元 |
| 动物实验(降脂功能全套) | 6000-8000 元 |
| 动物实验(降糖功能全套) | 7000-9000 元 |
| 降脂降糖联合评价 | 9000-10000 元 |
| 加急服务(缩短周期 30%) | 加收 30%-50% |
二、费用影响因素
检测报价受以下核心因素制约:
- 试验模型:动物实验需饲养管理、伦理审查与病理分析,成本高于细胞实验。
- 指标数量:血糖、血脂、胰岛素、肝糖原等检测项目越多,试剂与人工成本越高。
- 资质与周期:具备 CMA/CNAS 资质的实验室流程规范,加急服务需额外付费。
三、检测标准
产品执行标准概览:
- GB/T 20380-2006 保健食品功能评价方法(降血糖、降血脂相关指标)
- 《保健食品检验与评价技术规范》(2003 年版)辅助降血糖/降血脂功能评价部分
- WS/T 461-2014 肥胖症筛查标准(参考用于降脂效果评估)
- T/CHC 003-2019 保健食品原料目录 血糖血脂调节类
- 可根据客户需要标准进行检测
产品介绍
降脂降糖功能测试是评价食品或保健食品调节血脂、血糖代谢能力的重要方法,核心指标包括空腹血糖、糖耐量、总胆固醇、甘油三酯、低密度脂蛋白等。该检测适用于宣称辅助降血糖、降血脂的功能食品、植物提取物、营养补充剂等产品,是产品注册备案、功效宣称与市场准入的关键依据。
总结
降脂降糖功能测试费用因试验模型、检测指标与机构资质而异,动物实验报价通常在 6000 至 10000 元区间。企业应根据产品定位与法规要求选择合适方案,优先选择具备专业资质与丰富经验的检测机构,确保数据科学可靠,支撑产品合规宣称与市场推广。
汇策集团轻工检测拥有 CNAS 和 CMA 双重资质,具备标准化动物实验平台与生化分析实验室,可规范开展降脂降糖功能测试全流程服务。技术团队经验丰富,设备先进,数据权威可靠,广泛服务于保健食品企业与研发机构。欢迎联系专业工程师获取定制检测方案。
alt="微信二维码">